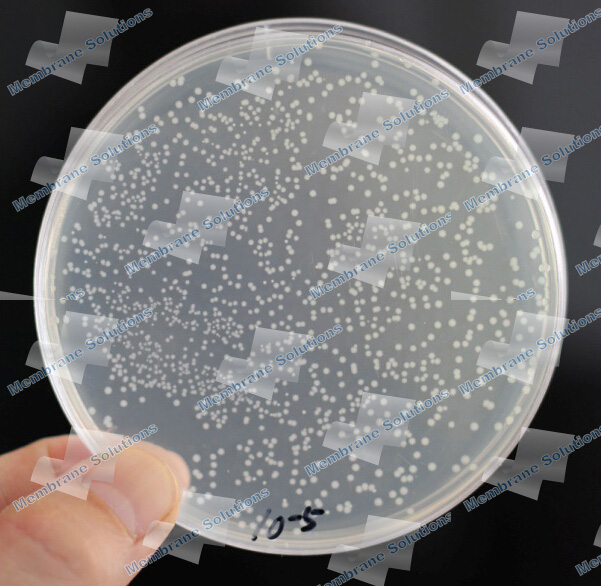
Validation Service
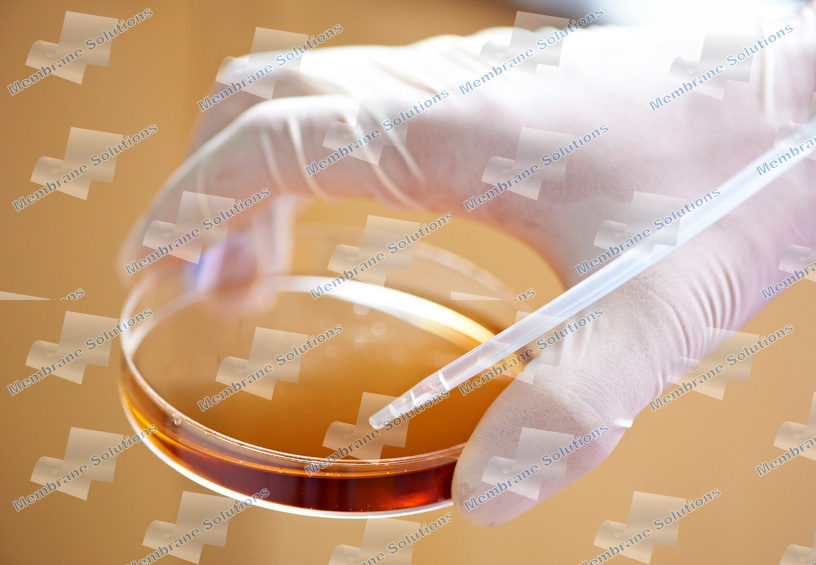
Validation Service

Validation Service
Request a QuoteDescription
MS appreciates the stringent regulatory demands for filter validation documentation in the biopharmaceutical industry. Our Validation Service Center are specially designed to comprehensively meet international regulatory requirements and are well supported by stringent Quality Management System which includes calibrated measuring and test equipments and auditable data generation. Our test and validation protocols are designed according to latest industry standards and we can provide a complete validation package ready for FDA or other agency's review, and generally validate and provide complete reporting in one month, consistently faster than our competitors.MS can provide your staff with the technical edge it needs to succeed in the highly competitive pharmaceutical industry, Our Validation Specialists develop the most effective testing protocols for each unique customer, provide complete validation guides and documentation packages, and even conduct staff training. Customer support may take place within our own laboratories(Located in Shanghai), or at the customer's facility.
Project

Extractables Analysis
Typically, extractables can not be evaluated directly in the actual product, Our Validation Lab use filters cartridge tested with the appropriate ‘Model Solvent’ to reproduce a worst-case situation. Both quantitative and qualitative information on extracted materials (non-volatile residue (NVR))must be generated.(FTIR、HPLC、UV .etc)
Typically, extractables can not be evaluated directly in the actual product, Our Validation Lab use filters cartridge tested with the appropriate ‘Model Solvent’ to reproduce a worst-case situation. Both quantitative and qualitative information on extracted materials (non-volatile residue (NVR))must be generated.(FTIR、HPLC、UV .etc)
Bacterial Viability
This test verifies the survival capacity of the organism selected for microbial challenge testing, either in the actual product formulation or a suitable product simulant, for the process time. The appropriate methodology is then chosen for the bacterial challenge study.
This test verifies the survival capacity of the organism selected for microbial challenge testing, either in the actual product formulation or a suitable product simulant, for the process time. The appropriate methodology is then chosen for the bacterial challenge study.
Bacterial Challenge Study
MS bacterial challenge study qualifies the ability of a filter medium to produce sterile filtrate in the process. A solution of the product or simulant is inoculated with the challenge organism at a concentration > 1 x 107 viable organisms/cm2 of filter membrane area. The challenge is performed on three filter membranes from different production batches, with at least one having a pre-filtration physical integrity test value at or near the filter production limit.
MS bacterial challenge study qualifies the ability of a filter medium to produce sterile filtrate in the process. A solution of the product or simulant is inoculated with the challenge organism at a concentration > 1 x 107 viable organisms/cm2 of filter membrane area. The challenge is performed on three filter membranes from different production batches, with at least one having a pre-filtration physical integrity test value at or near the filter production limit.

Filter Compatibility Assessment
A critical analysis of potential interactions between filter components and the pharmaceutical product is performed to ensure that the filter experiences no adverse effects in the pharmaceutical product. Compatibility test is determined by comparing integrity test results using the reference fluid. Tests are performed on the filter prior to and after worst-case exposure.
A critical analysis of potential interactions between filter components and the pharmaceutical product is performed to ensure that the filter experiences no adverse effects in the pharmaceutical product. Compatibility test is determined by comparing integrity test results using the reference fluid. Tests are performed on the filter prior to and after worst-case exposure.

Product Wet Filter Integrity Test Parameters
MS validation services for establishing product specific filter integrity test specifications help correlate product wetted integrity test values with those exhibited with the reference fluid (filter manufacturer specified) which in turn are already correlated to bacterial retention as per ASTM F-838-05 (Ref. MS Validation Guides).Filter integrity tests performed on critical filters immediately before and after batch filtration confirm performance to specification. In order to optimize processing, it may be more convenient to integrity test the filter cartridge wet with the product or process fluid. The reference fluid-wet value is correlated to bacterial retention information published in the filter validation guide. Product-wet values are then derived from actual test data, not theoretically calculated values, and correspondingly correlated to bacterial retention.
MS validation services for establishing product specific filter integrity test specifications help correlate product wetted integrity test values with those exhibited with the reference fluid (filter manufacturer specified) which in turn are already correlated to bacterial retention as per ASTM F-838-05 (Ref. MS Validation Guides).Filter integrity tests performed on critical filters immediately before and after batch filtration confirm performance to specification. In order to optimize processing, it may be more convenient to integrity test the filter cartridge wet with the product or process fluid. The reference fluid-wet value is correlated to bacterial retention information published in the filter validation guide. Product-wet values are then derived from actual test data, not theoretically calculated values, and correspondingly correlated to bacterial retention.

Filter Adsorptive Effects
Filters are selected to minimize adsorption and loss of product components is critical. MS Laboratory-scale filter tests can be used to generate adsorption profiles to help with filter selections and process qualification. Process conditions such as temperature and filter fluid contact time (flow rates) are simulated as these may have an impact on adsorption.
Filters are selected to minimize adsorption and loss of product components is critical. MS Laboratory-scale filter tests can be used to generate adsorption profiles to help with filter selections and process qualification. Process conditions such as temperature and filter fluid contact time (flow rates) are simulated as these may have an impact on adsorption.
